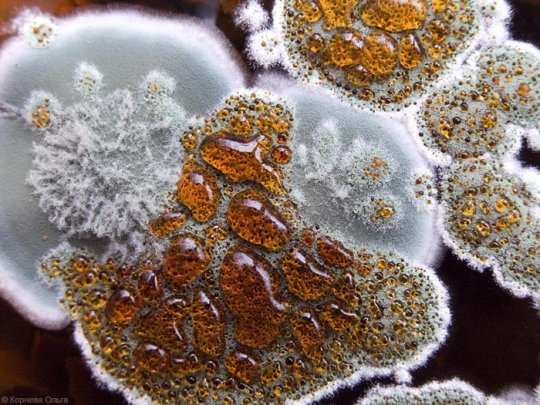
Нет - влажности и плесени!

Статья из спецраздела: Аллергия
Есть лиу вас аллергия на плесень или нет, ее воздействие может вызвать у вас раздражение глаз, кожи, носа, горла и легких.
Будь то слизистые черные пятна на занавеске в ванной, нечеткие белые пятна на поверхности пола, или небольшое оранжевое пятно, которое формируется на вашем кухонном водостоке-бытовая плесень является более чем просто пятном. В некоторых случаях, плесень может плохо повлиять на ваше здоровье,особенно,если у вас аллергия или астма.
Ниже советы, которые помогут вам избавиться от плесеньи и позаботиться о своем здоровье и доме.
Реакции на плесень: группы риска
Для людей, чувствительных к плесени, вдыхание или касание плесени может вызвать аллергические реакции, в том числе чихание, насморк, покраснение глаз, и сыпь на коже. На людей с более серьезными аллергическими реакциями плесень может повлиять куда серьезнее, в том числе могут появиться проблемы с дыханием .У людей с астмой, которые страдают аллергией на плесень, вдыхание спор также может вызвать приступ астмы.

Помимо людей с аллергией и астмой, другие люди могут быть более чувствительными к воздействию плесени, такие как:
- Младенци и дети
- Пожилие люди
- Люди, чья иммунная система чувствительна из-за ВИЧ-инфекции, рака, болезни печени, или химиотерапии
- Люди с хроническими болезнями легких
Невозможно избавиться от всех форм и спор плесени в вашем доме, но так как споры плесени не могут расти без влаги, то снижение влажности в вашем доме является лучшим способом для предотвращения или ликвидации плесени.Если же в вашем доме уже растет плесень, то очень важно очистить от нее дом и решить проблему с влажностью. Ведь,если если этого не сделать,то плесень появится снова.




